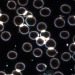

Non tutte le tecniche di caratterizzazione di nanoparticelle in soluzione sono uguali.
La tecnica TRPS di Izon Science offre misurazioni precise su singole particelle, un'analisi dettagliata delle dimensioni, della concentrazione e del potenziale zeta, rendendola...